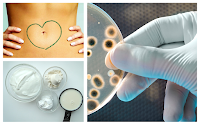

![]() |
| Gut health is "all the rage", lately. So even if it's true that this may be one of the most culpably neglected areas of research in the past century, we should still be careful not to hype the effect of the gut on your physique and health too much. |
Well, probiotics and the human microbiome (the one in the gut
and elsewhere) are all the rage, these days. Against that background, it's not really surprising that a probiotic supplement and thus a human microbiome modulator made it into the
SuppVersity news (
again). What may be surprising, though, is the fact that casein didn't just do the same, but that its appearance here in the news is
not due to its muscle building prowess. Rather than that, casein made the cut, because a recent study by Francois Mariotti, et al. shows that - even in comparison to whey protein - casein attenuates the potentially unhealthy postprandial triglyceride response to a mixed high-fat meal in healthy, overweight men.
![]()
Fiber for Female Fat Loss
![]()
Sweeteners & Your Gut
![]()
Foods, Not Ma- cros for the Gut
![]()
Lactulose For Gut & Health
![]()
Probiotics Don't Cut Body Fat
![]()
Is Gluten Intolerance Real?
- Cheesy! Casein keeps your trigs in check - Due to the interaction between elevated postprandial triglyceride levels, insulin resistance and cardiovascular disease, the results of the previously mentioned study by Mariotti et al. (2015) may be of interest not just for all of us. After all, the proposed mechanism of which the authors, scientists from the AgroParisTech speculate that it is a direct result of the same
"solubility of casein and its precipitation that forms a gel in the stomach [which have long been] known to influence its rate of absorption and postprandial protein metabolism in the context of regular, low-energy meals" (Mariotti. 2015),
as the marked effect on the chylomicron kinetics and decrease in postprandial TGs, a risk factor for cardiovascular disease, the French scientists observed in the study at hand.
![]() |
| Figure 1: Area under the curve for triglycerides (did respond), amino acids (didn't respond) and glucose (didn't respond) in 10 overweight subjects after consuming isocaloric high-energy meals with 15% of the energy from protein in form of casein (CAS), whey protein (WHE) or alpha-lactalbumin enriched whey (LAC | Mariotti. 2015) |
As you can see in Figure 1, the proteins which made up exactly 15% of the total energy content of the high-fat meal that was fed to 10 healthy overweight men with an elevated waist circumference (>94 cm) did not affect the subjects' postprandial plasma glucose, amino acids, insulin, or nonesterified fatty acid levels (which would, by the way, suggest that ingesting whey or an alpha-lactalbumin enriched whey protein with a meal ruins its amino acid absorption advantage). The study outcome that did differ, though were the postprandial triglycerides (TGs) levels, where the provision of casein lead to a highly significant 22% (+/- 10%) reduction in the 6-h area under the curve.
And I thought casein was bad for the heart? Well, there are in fact concerns that certain forms of casein - more specifically, beta-casein A1 - could be associated with ishaemic heart disease (McLachlan. 2001; Laugesen. 2003). Experimental evidence from humans that would confirm what epidemiologists suggests is yet lacking and the corresponding research happens to be pimped by New Zealand who have the lowest number of A1 cows in their herds |
learn more.
- As the authors point out, similar trends were shown for plasma chylomicrons [apolipoprotein (apo)B-48; P < 0.05], yet not for the postprandial oxidative stress (plasma hydroperoxides and malondialdehyde), endothelial dysfunction (salbutamol-induced changes in pulse contour analysis), or low-grade inflammation. This is also why it is as of yet only a logical, but hitherto unsupported hypothesis that consuming casein (micellar casein, not regular sodium or calcium caseinates) would also reduce one's cardiovascular disease risk. Eventually, it does yet appear to be the more reasonable adjunct to a full meal anyway - the purpose of the latter is after all to keep you satiated for a long time; and that's where casein is unquestionably a better choice than whey.
- Probiotics - 0.5% body fat reduction, and a 2.68 cm² reduction in subcutaneous fat area are not much, but they occurred in the absence of diet and exercise - If the trend continued and the 120 nondiabetic and overweight subjects Jung et al. divided into two groups: There was the probiotic group with 60 individuals who consumed 2 g of powder of two probiotic strains, L. curvatus HY7601 and L. plantarum KY1032, each at 2.5 × 109 cfu, twice a day. And there was the and a placebo group, likewise 60 individuals, who consumed the same amount of powder that did not contain any probiotics.
![]() |
| Figure 2: Changes in body composition according to waist measurement and CT scans - All values are relative changes in waist and fat area measure from week 0 to week 12 (Jung. 2015). |
Both groups were advised to take their supplements immediately after breakfast and dinner, but only the probiotic group saw relevant improvements in body fat at slow) pace - albeit a pace at which it would take them "only" 5 years to finally make it into healthy body fat zones.
![]() |
| Probiotics under urgently needed scrutiny: Many Probiotics Contain Antibiotic Resistant Bacteria. Plus: Number of Live Bacteria is up to 95% Below Label Claims | Learn more. |
Prebiotic supplements are not created equal! You may remember my recent article on (a) antibiotic resistances in supplemental probiotics and (b) the lack of viable bacteria in the different supplements the researchers analyzed. It should be obvious that these results mean that even though the study at hand appears to suggest that everyone should take probiotics, further research is needed before we can say which of the many pills on the market this should be... ah, and by the way. It is still not clear whether the same bacteria that are benefical for the obese are anywhere close to beneficial for lean athletic individuals. Rather than general recommendations, I expect the future of probiotic supple-ments to be
individual (based on diet and metabolic data).
- Ok, that's painfully slow, but given the fact that the food intake of both groups didn't differ significantly, it is still noteworthy that the 2 g of probiotic powder which contained contained 0.1 g of L. curvatus HY7601, 0.1 g of L. plantarum KY1032, 1.24 g of crystalline cellulose, 0.5 g of lactose, and 0.06 g of blueberry-flavouring agent made the subjects lose significant amounts of body fat, while their peers who received 2 g of a placebo powder that contained 1.34 g of crystalline cellulose, 0.6 g of lactose, and 0.06 g of blueberry-flavouring agent kept gaining.
![]() |
| Figure 3: The provision of the probiotic supplement did also trigger significant improvements in the above markers of cardiovascular disease risk - if it's not the small fat loss, it would thus be the potential CVD risk reduction that makes the use of probiotic supplements attractive especially for overweight individuals (Jung. 2015). |
In conjunction with the likewise statistically significant beneficial effects on health markers like LDL oxidation and LDL particle size which indicate significant improvements in cardiovascular disease risk, this is still the first non-sponsored study (the study was financed by Korean Ministry of Science) that shows that supplementing with commercially available probiotics in man may actually produce health-relevant beneficial effects.
![]() |
| Probiotics aren't for the overweight and obese, only. A recently discussed study, for example, showed that a patented multi-strain probiotic will reduce the fat gain on a 4-week "bulk" by more than 50% - and that's in twenty young men who consumed an extra 1,000kcal per day | more. |
You are kidding me, right? No, I am not. I know that neither casein nor probiotics appear to be game-changers, but eventually you will have to understand that the one trick, supplement or modification of your lifestyle cannot correct the 10,000 mistakes you have or even are still making. Losing fat and getting healthy is about taking one baby step at a time; and the studies by Mariotti et al. and Jung et al. describe two promising ways of taking another of these steps.
In that it would be great if we knew for sure how both of them work on a mechanistic (molecular) level. As of now, the only thing that appears to be certain, though, is that they act at the level of the gut. One by affecting the digestive process, the other by modifying the make-up of the intestinal microbiome of which more and more studies appear to suggest that it may not be triggering, but at least perpetuating the ill health effects of obesity |
Comment!References:
- Jung, Saem, et al. "Supplementation with two probiotic strains, Lactobacillus curvatus HY7601 and Lactobacillus plantarum KY1032, reduced body adiposity and Lp-PLA 2 activity in overweight subjects." Journal of Functional Foods 19 (2015): 744-752.
- Laugesen, Murray, and R. B. Elliott. "Ischaemic heart disease, Type 1 diabetes, and cow milk A1 β-casein." (2003).
- Mariotti, François, et al. "Casein Compared with Whey Proteins Affects the Organization of Dietary Fat during Digestion and Attenuates the Postprandial Triglyceride Response to a Mixed High-Fat Meal in Healthy, Overweight Men." The Journal of nutrition (2015): jn216812.
- McLachlan, C. N. S. "β-Casein A 1, ischaemic heart disease mortality, and other illnesses." Medical Hypotheses 56.2 (2001): 262-272.
![]()